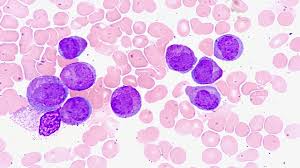

Pansitopeni, kanın üç ana hücresel bileşeninin (eritrositler, lökositler ve trombositler) seviyelerinin anormal derecede düşük olduğu bir durumdur. Her bir kan hücresinin belirli bir işlevi vardır:
Eritrositler (Kırmızı Kan Hücreleri): Oksijen taşıyan hücrelerdir. Oksijenin akciğerlerden vücudun çeşitli organlarına taşınmasını sağlar.
Lökositler (Beyaz Kan Hücreleri): Vücuda giren enfeksiyonlara karşı savaşan hücrelerdir. Bağışıklık sisteminin önemli bir parçasıdır.
Trombositler: Kanın pıhtılaşmasına yardımcı olan hücrelerdir. Kanamayı durdurma işlevi görür.
Pansitopeni, bu hücrelerin hepsinin seviyelerinin düşmesiyle karakterizedir. Bu durum, anemi (düşük kırmızı kan hücresi sayısı), enfeksiyonlara karşı savunmasızlık (düşük beyaz kan hücresi sayısı) ve kanama eğilimleri (düşük trombosit sayısı) gibi sağlık problemlerine yol açabilir. Pansitopeni, genellikle bir altta yatan hastalığın belirtisi olarak ortaya çıkar ve tedavi edilmeden bırakıldığında ciddi komplikasyonlara neden olabilir.
Pansitopeninin Nedenleri
Pansitopeninin çeşitli nedenleri olabilir. Bu nedenler, kan üretimini etkileyen hematolojik (kanla ilgili) sorunlardan, bağışıklık sistemi hastalıklarına, enfeksiyonlara ve hatta bazı ilaçlara kadar geniş bir yelpazeye yayılabilir. Pansitopeninin en yaygın nedenleri şunlardır:
1. Kemik İliği Sorunları
Kemik iliği, kan hücrelerinin üretildiği yerdir. Kemik iliği sorunları, pansitopeniye yol açabilir. Kemik iliği bozuklukları arasında şunlar yer alır:
Aplastik Anemi: Kemik iliğinin yeterli kan hücresi üretmemesi durumudur. Aplastik anemi, hem kırmızı kan hücreleri, hem beyaz kan hücreleri hem de trombositlerin sayısını azaltabilir.
Leukemi: Kan kanseri olarak bilinen bu hastalık, kan hücrelerinin kontrolsüz bir şekilde çoğalmasına yol açar ve kemik iliğini etkileyebilir. Bu durum, kan hücrelerinin üretimini engeller ve pansitopeniye neden olabilir.
Myelodisplastik Sendromlar: Kemik iliğindeki hücrelerin düzgün bir şekilde olgunlaşmadığı ve işlev göremediği bir grup hastalıktır. Bu sendromlar da pansitopeniye yol açabilir.

2. Bağışıklık Sistemi Hastalıkları
Bağışıklık sistemi hastalıkları, vücudun kendi kan hücrelerine saldırmasına neden olabilir. Bu tür hastalıklar şunları içerebilir:
Lupus: Bağışıklık sisteminin vücudun sağlıklı hücrelerine karşı saldırdığı, sistemik lupus eritematozus (SLE) gibi hastalıklar pansitopeniye neden olabilir.
Sjögren Sendromu: Bu hastalık da bağışıklık sisteminin vücuda zarar vermesine yol açabilir ve kan hücrelerini etkileyebilir.
3. Enfeksiyonlar
Bazı enfeksiyonlar, kemik iliğini etkileyerek pansitopeniye yol açabilir. Özellikle viral enfeksiyonlar, kemik iliği üzerinde baskı yaparak kan hücrelerinin üretimini engelleyebilir. Bu enfeksiyonlar arasında şunlar yer alır:
HIV: HIV, bağışıklık sistemini etkileyerek kan hücrelerinin üretimini bozabilir.
Hepatit Virüsleri: Hepatit B ve C virüsleri, kemik iliği üzerinde olumsuz etkiler yapabilir.
Epstein-Barr Virüsü (EBV): Bu virüs, mononükleoz hastalığına yol açar ve kemik iliğini etkileyerek pansitopeniye neden olabilir.
4. İlaçlar ve Kimyasallar
Bazı ilaçlar ve kimyasallar, kan hücrelerinin üretimini engelleyebilir ve pansitopeniye yol açabilir. Özellikle kemoterapi ilaçları, immünsüpresif tedaviler ve bazı antibiyotikler, kemik iliğini baskılayarak kan hücrelerinin üretimini düşürebilir.
5. Beslenme Eksiklikleri
Yetersiz beslenme, bazı besin maddelerinin eksikliği, kan hücresi üretimini engelleyebilir. Özellikle demir, folik asit ve B12 vitamini eksiklikleri, anemiye yol açarak pansitopeniyi tetikleyebilir.
6. Diğer Nedenler
Karaciğer Hastalıkları: Karaciğer hastalıkları, kan hücrelerinin üretimini olumsuz etkileyebilir.
Böbrek Yetmezliği: Böbrek hastalıkları, kan hücresi üretimi üzerinde de etkili olabilir.
İmmün Hemolitik Anemi: Bağışıklık sistemi, kırmızı kan hücrelerini yok edebilir ve bu da pansitopeniye yol açabilir.
Pansitopeni Belirtileri
Pansitopeninin belirtileri, düşen kan hücresi seviyelerine bağlı olarak değişebilir. Farklı kan hücrelerinin düşmesi, farklı belirtilerle kendini gösterebilir:
Düşük Kırmızı Kan Hücre Sayısı (Anemi): Yorgunluk, halsizlik, soluk cilt, nefes darlığı, baş dönmesi, çarpıntı gibi belirtiler görülebilir.
Düşük Beyaz Kan Hücre Sayısı (Lökopeni): Enfeksiyonlara karşı artan hassasiyet, ateş, titreme, boğaz ağrısı gibi belirtiler görülebilir. Bu durum, bağışıklık sisteminin zayıfladığını gösterir.
Düşük Trombosit Sayısı (Trombositopeni): Kolay morarma, kanamalar, burun kanamaları, diş eti kanamaları gibi belirtiler görülebilir. Ayrıca, kanama durdurulması zor hale gelebilir.
Bu belirtiler, hastalığın şiddetine bağlı olarak farklılık gösterebilir. Eğer bu belirtilerden bir veya daha fazlası görülüyorsa, bir doktora başvurmak önemlidir.
Pansitopeni Teşhisi
Pansitopeni teşhisi, genellikle kan tahlili ile konur. Tam kan sayımı (CBC) testi, kanın üç ana hücresel bileşeninin (eritrositler, lökositler, trombositler) seviyelerini ölçer. Bu test, pansitopeninin varlığını ve şiddetini gösterir.
Pansitopeni teşhis edildikten sonra, altta yatan nedeni belirlemek için ek testler yapılabilir. Bu testler arasında şunlar yer alır:
Kemik İliği Biyopsisi: Kemik iliğinin sağlıklı çalışıp çalışmadığını kontrol etmek için yapılır. Kemik iliği biyopsisi, hematolojik hastalıkların teşhisinde önemli bir adımdır.
Viral Testler: HIV, hepatit gibi viral enfeksiyonlar araştırılabilir.
Genetik Testler: Bazı kalıtsal hastalıklar da pansitopeniye neden olabilir. Bu nedenle genetik testler yapılabilir.
İmmünolojik Testler: Bağışıklık sistemi hastalıklarını araştırmak için yapılır.
Pansitopeni Tedavi Yöntemleri
Pansitopeninin tedavisi, altta yatan nedene bağlı olarak değişir. Pansitopeniye yol açan hastalığın tedavi edilmesi, genellikle kan hücresi seviyelerinin normale dönmesini sağlar.
1. Kemik İliği Sorunları için Tedavi
Kemoterapi veya Radyoterapi: Kanser hastalıkları (örneğin, lösemi) nedeniyle pansitopeni gelişmişse, kemoterapi veya radyoterapi ile tedavi gerekebilir.
Kemik İliği Nakli: Aplastik anemi gibi kemik iliği yetmezliği durumlarında kemik iliği nakli gerekebilir.
2. Bağışıklık Sistemi Hastalıkları için Tedavi
Bağışıklık sistemi hastalıklarında, immünsüpresif ilaçlar veya kortikosteroidler kullanılabilir. Bu tedavi, bağışıklık sisteminin kan hücrelerine zarar vermesini engellemeye yardımcı olabilir.
3. Enfeksiyonlar için Tedavi
Viral enfeksiyonlar tedavi edildikçe, kemik iliği üzerindeki baskı azalabilir. Antiviral tedavi veya antibiyotik tedavi uygulanabilir.
4. Kan Ürünleri ve Kan Transfüzyonu
Pansitopeni nedeniyle ciddi anemi, lökopeni veya trombositopeni gelişen hastalara kan transfüzyonu yapılabilir. Kan ürünleri (kırmızı kan hücreleri, trombositler) hastanın durumuna göre verilebilir.
5. Beslenme Tedavisi
Beslenme eksiklikleri nedeniyle pansitopeni gelişmişse, vitamin ve mineral takviyeleri (örneğin, B12 vitamini, folik asit ve demir) tedavi olarak verilebilir.
6. Genel Destek Tedavisi
Pansitopeni tedavisinde hastanın genel durumunu iyileştirmek için destek tedavileri uygulanabilir. Bu tedavi, fiziksel güç kaybını önlemeye ve enfeksiyon riskini azaltmaya yöneliktir.
Pansitopeni, kan hücrelerinin sayısının düşmesiyle karakterize edilen ciddi bir durumdur. Altta yatan birçok hastalık bu durumu tetikleyebilir ve tedavi edilmediği takdirde ciddi sağlık sorunlarına yol açabilir. Pansitopeni tanısı konduğunda, hastanın altta yatan nedeni belirlemek ve tedavi etmek önemlidir. Doğru tedavi ile çoğu hasta iyileşebilir ve kan hücreleri seviyeleri normale dönebilir.

